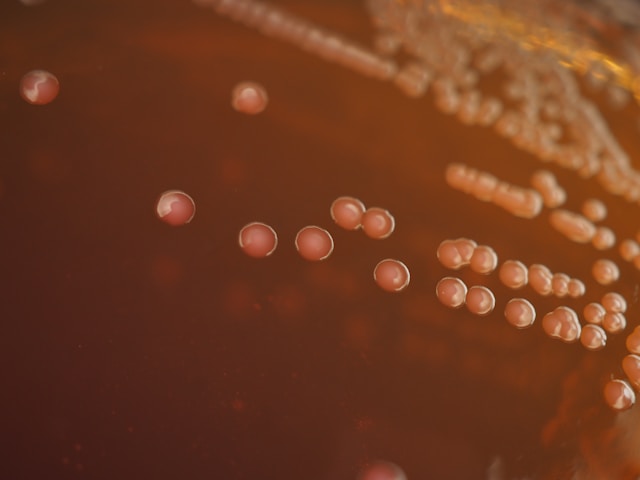

В США начали выявлять шигеллы с широкой лекарственной устойчивостью к большинству классов антибиотиков. Центры по контролю и профилактике заболеваний США (CDC) сообщили об отсутствии возможных вариантов лечения среди одобренных пероральных антибиотиков.
Центры по контролю и профилактике заболеваний США (CDC) сообщили о появлении и росте числа шигелл с широкой лекарственной устойчивости. Для лечения вызванных ими инфекций не существует одобренных пероральных антибиотиков.
Первые суперустойчивые бактерии выделены у пациентов в 2011 году. Их число выросло до 8,5% в 2023 году среди 17 тысяч изолятов шигелл с признаками устойчивости к антибиотикам.
Шигеллы с широкой лекарственной устойчивостью резистентны к ампициллину, азитромицину, цефтриаксону, ципрофлоксацину и триметоприму-сульфаметоксазолу. Для лечения инфекций, вызванных патогенами, не существует одобренных пероральных противомикробных препаратов.
Изменились также характеристики заболевания. Предыдущие вспышки шигеллеза случались в основном среди детей, были вызваны чувствительными к антибиотикам патогенами. Случаи заражения штаммами с широкой лекарственной устойчивостью сейчас происходят в основном среди взрослых.
Среди патогенов с широкой лекарственной устойчивостью преобладали Shigella sonnei (65,9%), остальные возбудители представлены Shigella flexneri. Средний возраст пациентов с выделенными устойчивыми изолятами составил 41 год. Большинство из них были мужчинами, которые не выезжали за пределы страны (86 %).
Шигеллы легко передаются, подчеркивают CDC, гены устойчивости могут распространяться на другие кишечные бактерии. Это делает патогенымс широкой лекарственной устойчивостью угрозой общественному здравоохранению.
Шигеллез — высококонтагиозная инфекция, вызванная грамотрицательными бактериями. Для заражения достаточно всего 10 бактерий. Инфицирование происходит фекально-оральным и половым путем, а также через воды, пищу и котнаминированные предметы.
Назначение антибиотиков необходимо при тяжелом течении инфекции или при высоком риске передачи инфекции и высоком потенциальном риске быстрого распространения инфекции, сообщают CDC.
В России также выявляли полирезистентные микробы, устойчивые ко всем доступным антимикробным препаратам или единственному возможному варианту лечения. Однако при мониторинге 2024 года выявлены единичные такие штаммы.
Так, эксперты сообщили о выявлении единичных штаммов E. faecium, которые устойчивы ко всем доступным противомикробным препаратам, включая «резервные».













